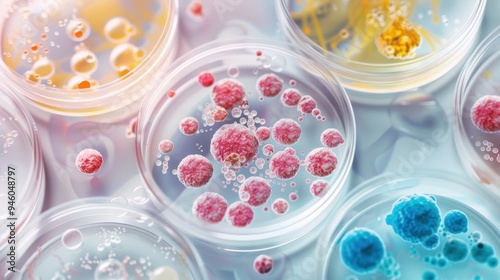

Download sample
File Details
Published: 2024-08-28 15:40:59.886109 Category: Science Type: Illustration Model release: NoShare
Microbial Diversity in Petri Dish, an intricate illustration showcasing various microorganisms developing unique, pale colonies, highlighting their growth patterns and interactions.
Contributor: Mitzuha
ID : 946048797
